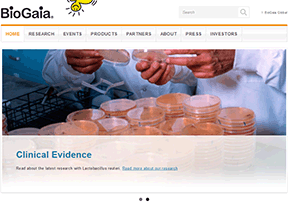

瑞典商业欧洲网站大全

-
商业 特瑞堡集团
国家:瑞典
更新日期:2017-09-09
特瑞堡集团(Trelleborg AB)是瑞典的一家化工企业,成立于1905年,总部位于斯科讷省特雷勒堡,主要生产聚合物与橡胶。特瑞堡集团旗下分为涂层系统、密封系统、轮胎系统、工业系统和海洋工程与建设五个事业群。

-
商业 萨博考库姆公司
国家:瑞典
更新日期:2017-07-16
萨博考库姆公司(SAAB Kockums AB)是瑞典的一家军工企业,成立于1840年,现为萨博集团旗下公司。萨博考库姆公司主要生产战列舰、护卫舰、潜艇等。

-
商业 沃尔沃集团
国家:瑞典
更新日期:2017-06-13
沃尔沃集团(AB Volvo)是瑞典的一家跨国制造公司,成立于1927年,总部位于哥德堡,产品包括卡车、客车、建筑设备、船舶、航天航空设备等,此外还提供金融、IT等服务。

-
商业 伊莱克斯
国家:瑞典
更新日期:2017-05-24
伊莱克斯(Electrolux)是全球著名的电器设备制造商,其中厨房设备、清洁 洗涤设备及户外电器设备等业务均名列世界前茅。伊莱克斯是由爱尔克•温尔格林于1919年创建的,总部设在瑞典的斯德哥尔摩,是由Lux有限公司和Elektromekaniska有限公司合并而成。

-
商业 北极狐_Fjallraven
国家:瑞典
TAG: 北极狐 Fjallraven 品牌 运动 户外 服饰
更新日期:2017-05-05
北极狐(Fjällräven)是瑞典著名户外运动品牌,成立于1960年,总部位于恩舍尔兹维克,主要生产户外运动服装和户外装备。

-
商业 利乐公司
国家:瑞典
更新日期:2016-03-04
利乐包装公司(Tetra Pak)是全球著名包装产品制造商,由卢本·劳辛(Ruben Rausing)创建于1943年,总部位于瑞典pully,隶属于利乐拉伐集团。利乐著名包装产品包括利乐无菌砖、利乐传统包等。

-
商业 山特维克
国家:瑞典
更新日期:2017-03-30
山特维克集团(Sandvik)是全球著名制造企业,总部位于瑞典山特维肯市。山特维克的产品包括金属切削工具、工程机械、不锈钢材料、特种合金、传动系统等,山特维克矿山机械、山特维克刀具等产品在全球范围内享有盛名。
-
商业 拜奥_BioGaia
国家:瑞典
TAG: 拜奥_BioGaia 品牌 健康 生物
更新日期:2017-03-16
拜奥(BioGaia)是瑞典的一家生物技术公司,成立于1990年,总部位于斯德哥尔摩,主要生产益生菌相关产品。

-
商业 斯德哥尔摩证券交易所
国家:瑞典
TAG: 斯德哥尔摩证券交易所 证券 证交所
更新日期:2017-01-03
斯德哥尔摩证券交易所(Stockholm Stock Exchange)瑞典著名的证券交易市场,以“纳斯达克斯德哥尔摩”(Nasdaq Stockholm)名字运营,隶属于纳斯达克集团旗下,于1863年创建,历史悠久。

-
商业 亚萨合莱
国家:瑞典
更新日期:2016-12-12
亚萨合莱(ASSA ABLOY)是瑞典的一家上市公司,成立于1994年,总部位于斯德哥尔摩,由瑞典ASSA公司与芬兰Abloy公司合并而成。亚萨合莱产品包括锁具、自动门、安全门等,是全球最大的智能锁和安防解决方案供应商之一。

-
商业 阿特拉斯•科普柯集团
国家:瑞典
TAG: 阿特拉斯•科普柯集团 工程机械
更新日期:2016-12-11
阿特拉斯•科普柯集团(Atlas Copco)著名跨国工业集团,于 1873 年成立,总部设在瑞典首都斯德哥尔摩,在瑞典、英国和德国上市,其四大事业领域包括压缩机技术领域、租赁服务领域、工业技术领域、矿山与工程技术领域等。其主要股东为银瑞达集团。

-
商业 Emmaljunga
国家:瑞典
TAG: Emmaljunga 母婴 育儿
更新日期:2016-11-04
Emmaljunga瑞典顶级婴儿车品牌,于1925年创立,历史悠久,以安全、舒适和极佳的减震效果著称,在北欧具有很高的市场占有率。

-
商业 挪威第二电信
国家:瑞典
TAG: 挪威第二电信
更新日期:2016-11-01
挪威第二电信(Tele2)瑞典著名的电信营运商,于1993年创立,总部位于瑞典的斯德哥尔摩,在2014年《福布斯》全球企业2000强中排名第1417位。

-
商业 爱立信
国家:瑞典
更新日期:2016-09-18
爱立信集团(Telefonaktiebolaget L. M. Ericsson)是世界著名的电信系统与设备制造商,创建于1876年,总部位于瑞典斯德哥尔摩。1990年代,爱立信在全球手机市场占有率高居第三位,2001年与日本索尼合组为索尼爱立信,2012年将持有的股权售给索尼,专注于提供无线网络和移动电信设备。爱立信在2G、3G、4G方面拥有大量专利。在2013年财富世界500强排名中,爱立信集团排在第333位。

-
商业 瑞典北欧斯安银行
国家:瑞典
更新日期:2016-08-14
瑞典北欧斯安银行(Skandinaviska Enskilda Banken;简称:SEB)北欧著名的金融集团,主要提供网上银行、储蓄和企业投资等核心业务,在2012年《环球金融》(Global Finance)“全球最安全50家银行”排行中榜上有名;在2014年《福布斯》全球企业2000强排行榜中位居第259名。

-
商业 哈苏
国家:瑞典
更新日期:2016-06-20
哈苏(Hasselblad)是全球著名相机品牌,成立于1841年,总部位于瑞典哥德堡。1880年代开始销售伊士曼柯达公司产品,二战期间开始发展相机业务,发展航空用相机。在阿波罗登月任务中,几乎所有照片都用改良后的哈苏相机拍摄的。

-
商业 H&M
国家:瑞典
更新日期:2016-04-24
H&M(Hennes & Mauritz AB)是瑞典的一家时装公司,成立于1947年,总部位于瑞典斯德哥尔摩。H&M是全球最大的休闲服饰品牌之一,在欧洲、美洲、亚洲拥有超过3000家店铺,H&M的产品以其物美价廉著称。



